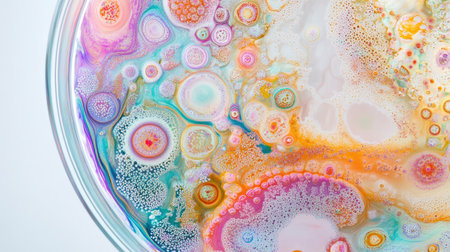
Petri dish with colorful bacterial colonies spreading in intricate patterns, perfect for scientific or educational themes, with copy spaceの素材

素材 - Petri dish with colorful bacterial colonies spreading in intricate patterns, perfect for scientific or educational themes, with copy space
作品情報
Petri dish with colorful bacterial colonies spreading in intricate patterns, perfect for scientific or educational themes, with copy space
- ID:258463100
- 作品種別:
- 作者名:Thipparat Thippayasan
キーワード
- abstract
- abstract backgrounds
- art
- art and craft
- backgrounds
- bacterium
- biology
- bubble
- circle
- close-up
- colony
- color image
- colors
- creativity
- culture
- directly above
- dish
- essential oil
- fantasy
- growth
- healthcare and medicine
- horizontal
- ink
- inspiration
- japan
- laboratory
- medicine
- microbiology
- milk
- mixing
- modern
- multi colored
- no people
- paint
- petri
- petri dish
- psychedelic
- research
- sample
- science
- shape
- sphere
- studio shot
- uk
- variation
- vibrant color
- water
- yellow
類似作品
close-up of vib...
Background with...
Close up petri ...
close-up of col...
Vibrant dots of...
A petri dish te...
Petri dish with...
microbial cultu...
A close-up of a...
A vibrant displ...
petri dish with...
The mesmerizing...
Close-up of a P...
Petri dish with...
Abstract view o...
top view of a p...
Abstract labora...
Close up petri ...
close-up of vib...
Shimmer bubbles...
top view of a p...
A petri dish wi...
A Colorful repr...
Close-up of Pet...
A glass bowl fi...
petri dish with...
A vibrant and c...
Colorful variet...
A tray filled w...
A glass dish wi...
A close-up of c...
Laboratory tech...
Petri dishes co...
Microbiology - ...
The mesmerizing...
Colorful variet...
A vibrant abstr...
Test tubes with...
The mesmerizing...
Petri dish with...
Petri dishes wi...
A vibrant petri...
Pipette with dr...
microbial cultu...
Vivid petri dis...
Transparent gla...
Abstract backgr...
Fluorescent pai...
An overhead sho...